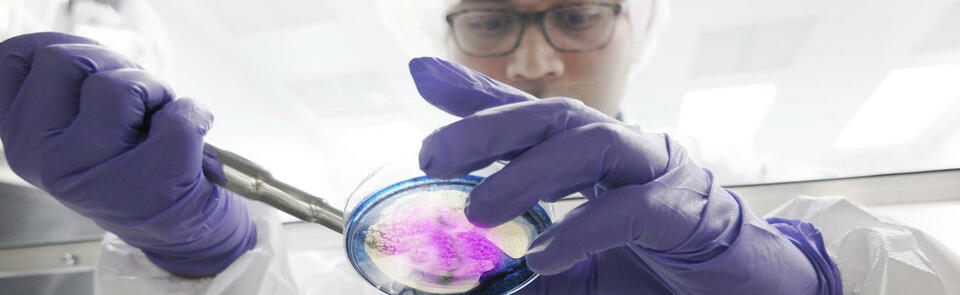

Research themes and projects
This DTP is the first dedicated student-centred postgraduate research training programme in Translational Research for Global Health in the UK with a focus on developing “bridge scientists” able to translate scientific innovation into beneficial impact on health. This ambition is also complimented by the DTP’s specific focus on the development of core quantitative skills that act as a common “language” for students that come from diverse backgrounds, to facilitate interdisciplinary research across disciplines and sectors.

The DTP provides access and support to students to enable delivery of novel and impactful global health focused translational projects within our wide international network of overseas programmes and partners, bridging distance between traditionally separate disciplines in alignment with several of the MRC Strategic Skill Priority Areas. Student’s projects not only reflect traditional research activities in global infections, including antimicrobial resistance, prevention and early detection, and precision medicine, but also in a broader range of research topics including non-communicable diseases, and transdisciplinary projects that involve health and socioeconomic factors, environmental change and culture, involving wider NGO, charity and private-sector participation. Our core of supervisors that support the DTP have developed extensive global links with academic and non-academic partners including governmental, nongovernmental organisations (NGOs), product development partnerships (PDPs) and industry (large pharma and SMEs), predominantly in LMICs. These international links have been leveraged to provide ideal training environments for our students, for example, our current DTP cohort have worked with numerous overseas partners, e.g. in Malawi, Kenya, India, Uganda, Nigeria, Cameroon, Switzerland and Brazil.
By extension, translational research is collaborative by definition and has always been delivered through strategic partnerships. For example, LSTM has developed robust partnerships with Pharma (GSK, Pfizer, Astra Zeneca, Abbott/Abbvie),
Agrochemical (Bayer, Syngenta, Sumitomo) and smaller support companies (Biofocus, Anacor), as well as a number of governmental (e.g.DfID (now FCDO), PHE (now UKHSA), NIHR) and international agencies and non-governmental bodies (WHO, Médecins Sans Frontières, (MSF), Medicines for Malaria Venture (MMV), TB Alliance (TBA), PATH). In Lancaster, CHICAS is a partner in the Manchester-led arm of the Farr Institute (now Health Data Research UK) and in LU’s cross-faculty Data Science Institute. Through this institute trans-disciplinary work is undertaken with non-academic partners both within the UK and internationally.
Candidates applying for the current admission round should select at least one project (but may select up to three) in order to proceed with the application form. Your selection(s) is/are an expression of interest in a project area and does not secure a specific project to your application or admission. Project allocations will be confirmed upon successful offer, and will be developed beyond the initial project outline during Year 1 and beyond.